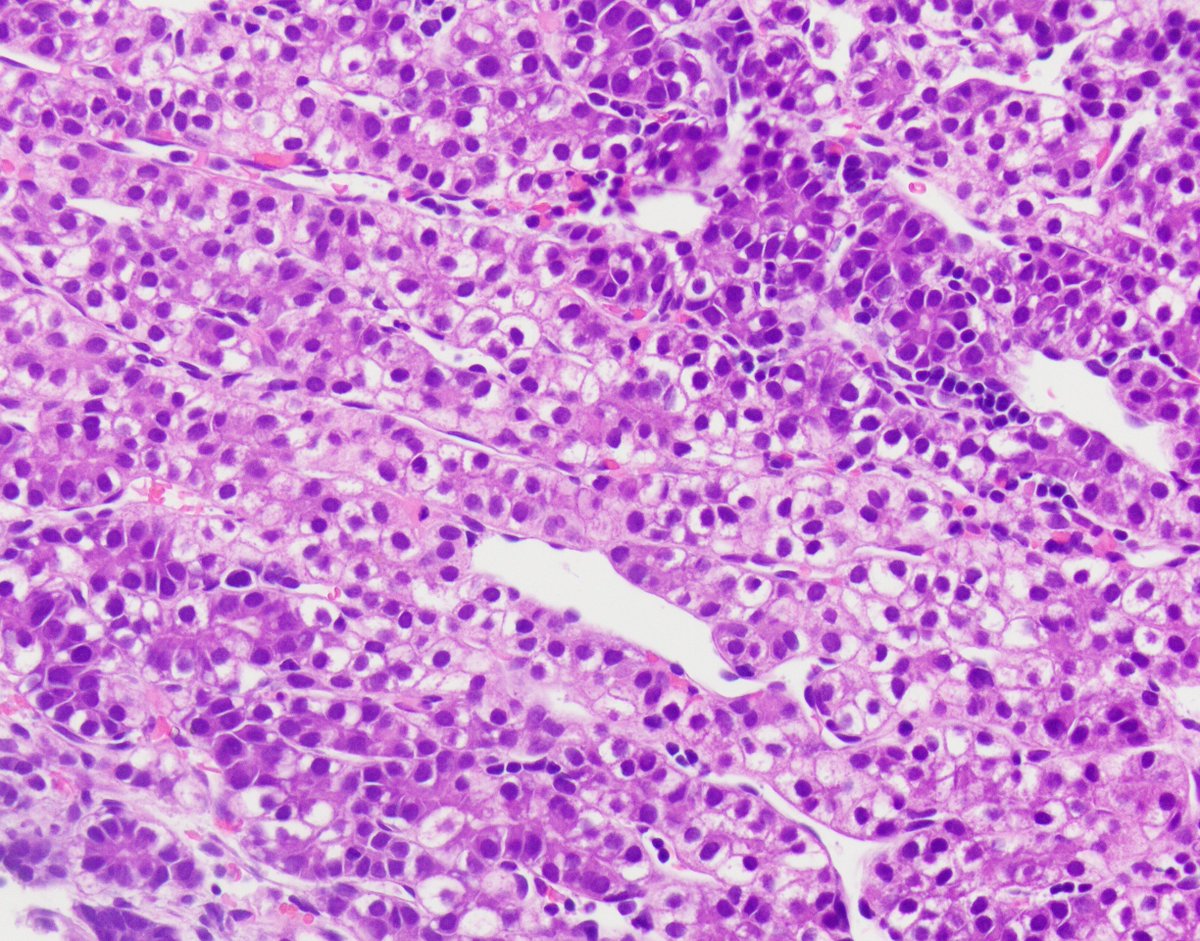
Ami Patel tweet media

Sabitlenmiş Tweet

@AlexAndersonMD The most energizing thing for me is when you’re welcomed home with a positive energy. Couldn’t ask for better 🤗
English
Priya P. Patel
682 posts

@PCubedMD
Interventional Pulmonologist @InovaHealth & @InovaSchar. Alumni of @HarvardIP. Dreamer, eventual doer, pizza lover, and wine enthusiast. @CHESTOncology





FANTASTIC Pneumothorax Session with leaders in the field!!! @accpchest #CHEST2023 @DukeRadiology @DukePulmFellows @YCGaryLee @criticalMD @PCubedMD . Learned so much! 💥💥💥💥🩻 @AAB_IP #fullhouse #standingroomonly

Tweet a random photo from your phone with no explanation















